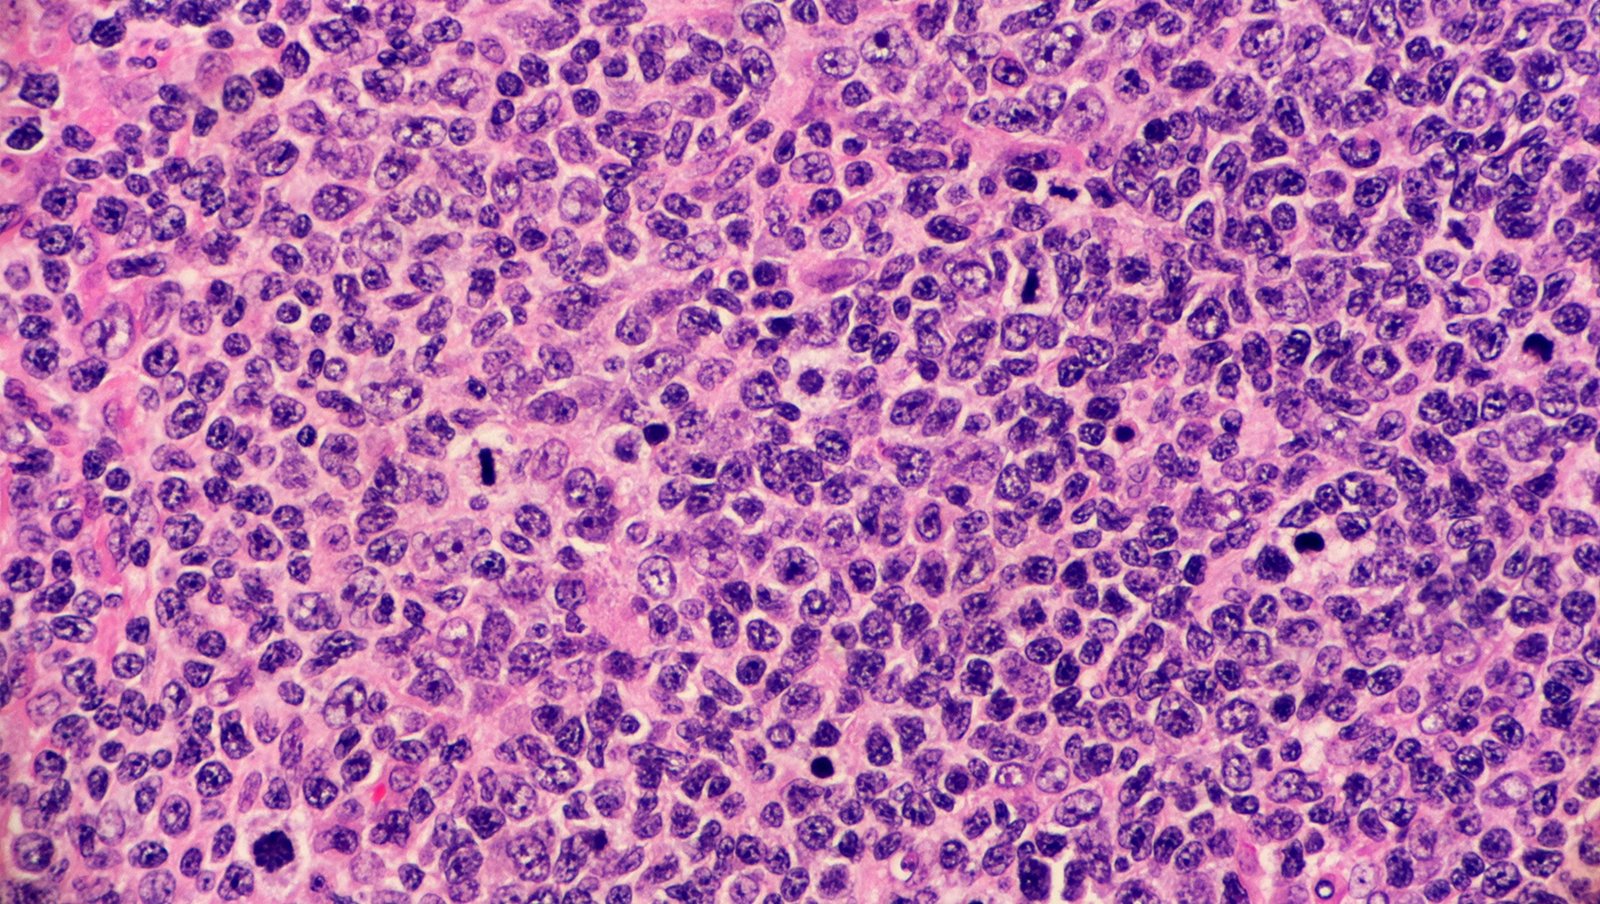
Interim PET w chłoniaku grudkowym jako narzędzie w strategii leczenia dostosowanego do odpowiedzi

Podczas gdy większość pacjentów z chłoniakiem grudkowym (follicular lymphoma, FL) uzyskuje bardzo dobre wyniki po zastosowaniu chemioimmunoterapii (chemoimmunotherapy, CIT) pierwszej linii, nadal istnieje pewna podgrupa pacjentów, która doświadcza wczesnej progresji choroby, co wiąże się ze znacznym pogorszeniem rokowania.
Materiał przeznaczony wyłącznie dla pracowników służby zdrowia
Ten materiał jest dostępny dla zarejestrowanych użytkowników.
Zaloguj się
Szanowni użytkownicy,
część materiałów udostępnianych na naszym portalu jest przeznaczona
wyłącznie dla lekarzy.
Wynika to z regulacji prawnych, do których musimy się stosować.
Jeśli nie jesteś lekarzem, zachęcamy do korzystania z przygotowanych przez nas materiałów dostępnych w zakładce dla pacjentów.











